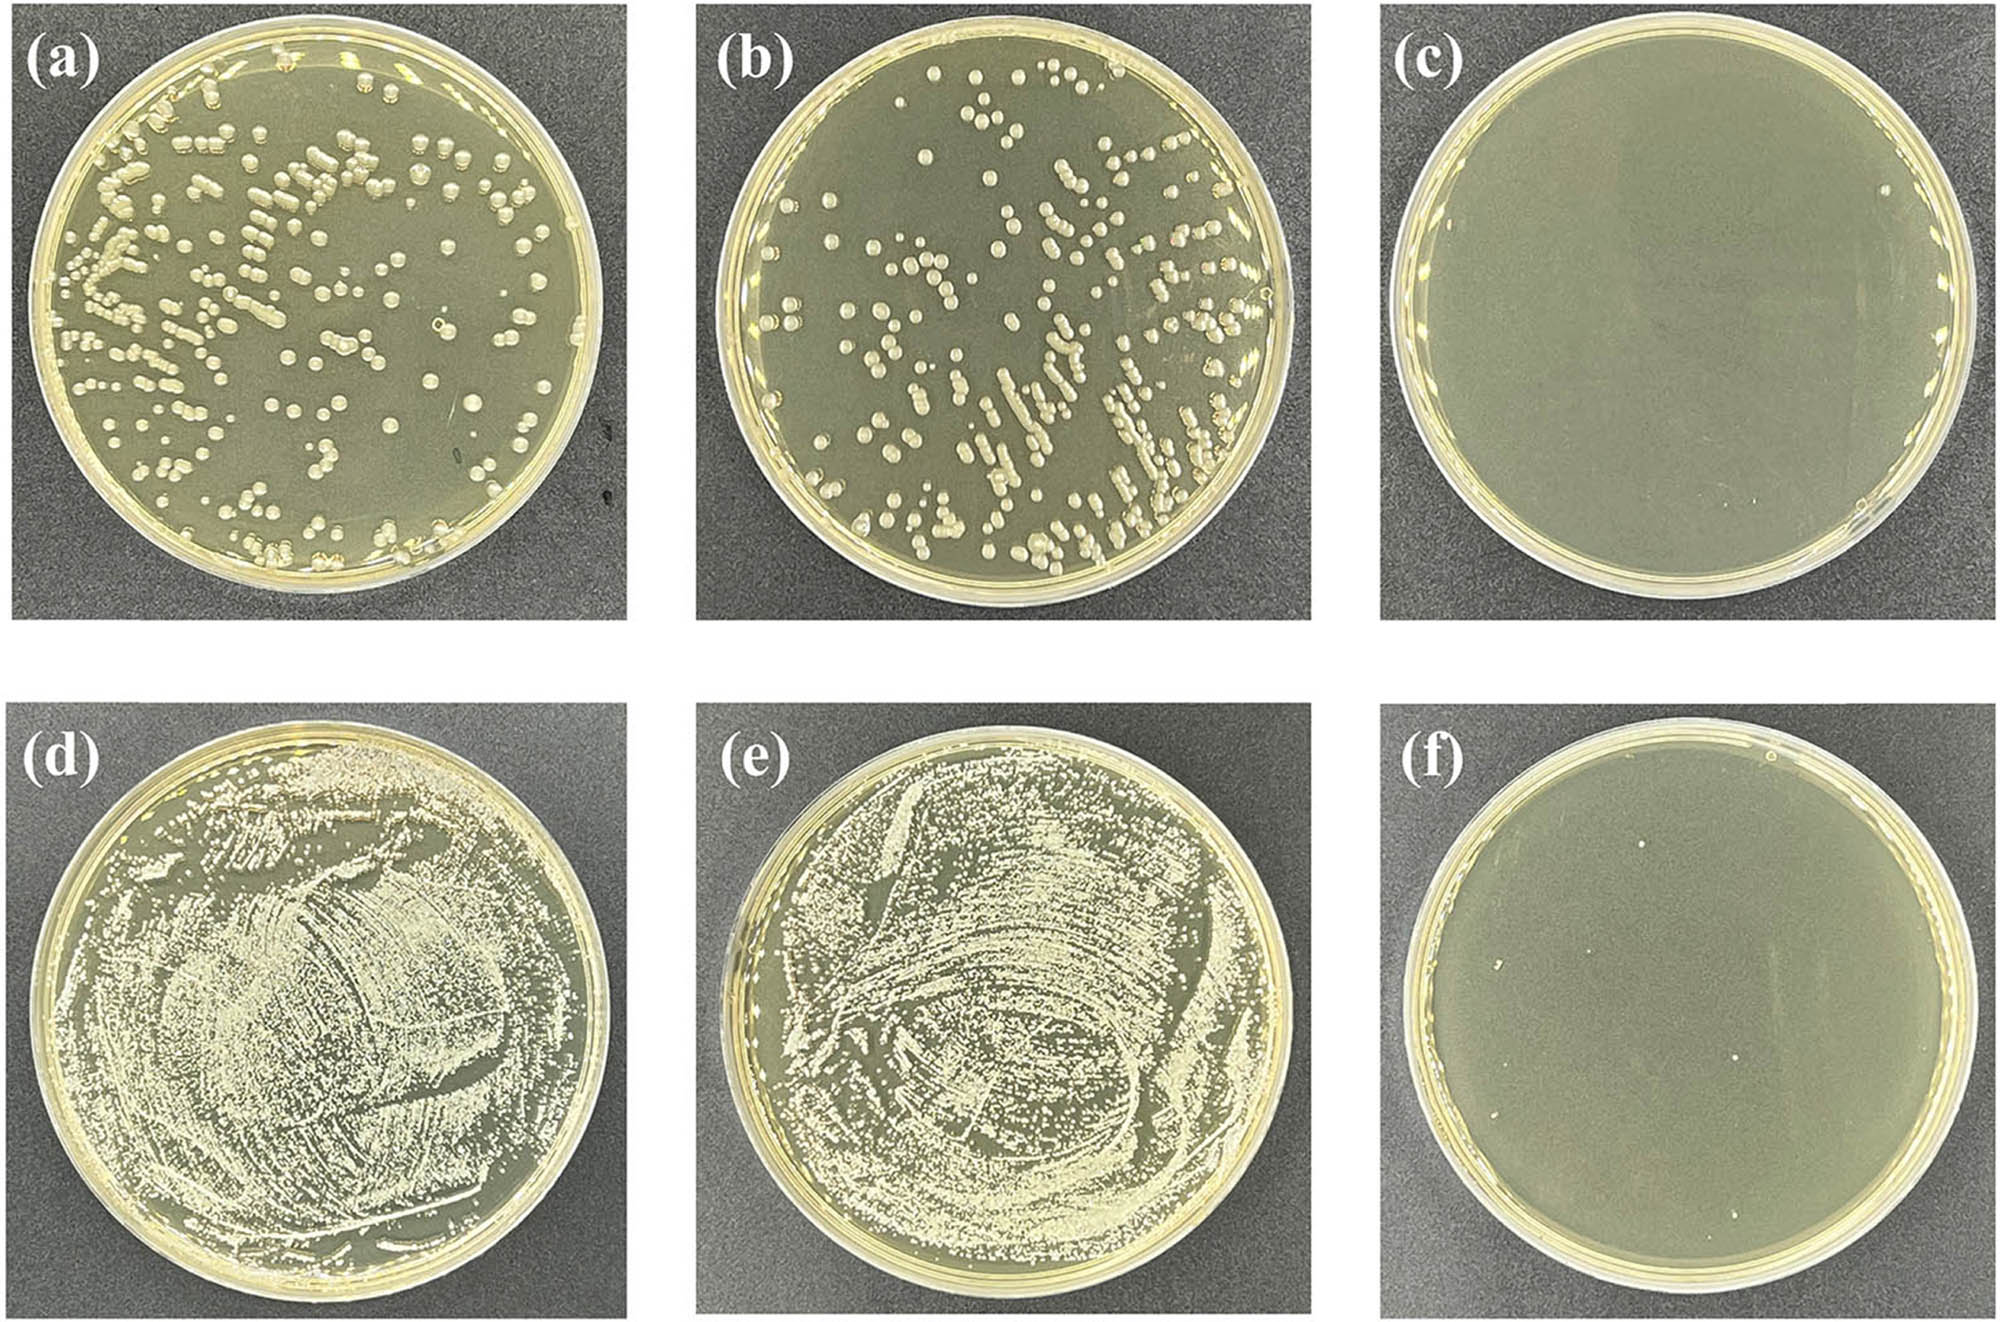

Abstract
Polyamide composite reverse osmosis (RO) membranes occupy an important position in water treatment. However, membrane fouling, especially biofouling, can lead to a significant decrease in membrane permeability. Therefore, reducing biological contamination is a significant and important property of an RO membrane. In this article, a hypothesis on the development of a new kind of RO membrane for antibacterial purposes was prepared by the modification of gallic acid (GA) and silver nanoparticles (AgNPs). Then, experiments were carried out to verify the hypothesis, getting a modified RO membrane with the composite of GA@AgNPs. The water flux of the GA@AgNPs RO membrane was 31.1 L·m−2·h−1, which was 46.7% higher than that of the original membrane, while the rejection rate of salt remained at 93.8–97.6%. Moreover, the GA@AgNPs RO membranes exhibited outstanding antibacterial properties with more than 99.9% antibacterial efficiency against both Escherichia coli and Staphylococcus aureus. Our work provides a new idea for solving the problem of biofouling RO membranes.
1 Introduction
The current global shortage of freshwater resources has affected the sustainable development of human beings (1). Therefore, seawater and some wastewater were treated by evaporation and reverse osmosis (RO) membrane technology to obtain enough freshwater for life and industrial manufacturing (2). Polyamide RO composite membranes are usually formed by the interfacial polymerization of m-phenylenediamine (MPD) in the water solution and trimesoyl chloride (TMC) in the organic solution on the polysulfone (PSF) support layer, and the preparation method is simple and feasible. In the application of RO membrane technology, polyamide RO membranes occupy a dominant position in the RO membrane market due to their advances in higher salt rejection, a longer working life, and a wider field of application. However, polyamide RO membranes are naturally prone to fouling, which seriously affects their working efficiency and becomes a major obstacle to their popularization and application (1).
Polyamide RO membrane fouling is caused by many reasons, among which biofouling is the main reason. Severe biofouling can lead to a significant loss of water permeability and thereby reduce the mass and quality of the generated freshwater (3,4). To reduce biofouling, physical and chemical pretreatments and water disinfection are always applied to prevent biofouling (5). However, the water treated by those methods still contained a small number of microorganisms, which should grow and reproduce continuously on the membrane surface, and also lead to membrane fouling (6). Therefore, besides the general pretreatments, it is significantly important for the preparation of a polyamide RO membrane with the property of being antibacterial for reducing biofouling.
To obtain an antibacterial polyamide RO membrane, modification methods such as surface modification and various nano-doping have been developed (6). In particular, silver nanoparticles (AgNPs), as a nanomaterial with strong antibacterial properties, has attracted more and more attention from researchers (7). However, AgNPs have poor dispersibility; hence, directly introducing AgNPs into a polyamide composite membrane should cause an aggregation, which makes it difficult to form a complete selective layer to fully connect to the bacteria for their death (8,9).
In order to solve the problem of AgNPs aggregation, researchers developed preparation methods such as physical adsorption, layer-by-layer coating, and in situ incorporation. For instance, Yin et al. reported that the grafting of AgNPs to a thin-film composite membrane surface by using a bridging chemical reagent (cysteine) is easily contaminated to form covalent bonds with AgNPs (10). Ben-Sasson et al. prepared uniformly covered AgNPs on a polyamide RO membrane by reducing silver ions in solution (11). Yang et al. functionalized with poly(3-sulfopropyl methacrylate potassium salt) via atom transfer radical polymerization followed by in situ immobilization of AgNPs using a strong reducing agent (12). Although those methods can avoid the agglomeration of AgNPs, they require some strong reducing agents or bridging reagents, and those applied agents and bridging agents present high costs and might cause environmental pollution.
Therefore, it is necessary to develop a new method to prepare an RO membrane with antibacterial AgNPs to reduce membrane fouling. Gallic acid (GA) is a natural polyphenol in plants, such as legumes, vegetables, fruits, and beverages, which can act as a stabilizer for nanoparticles (13,14). As a hypothesis, GA and AgNPs–modified RO membrane (GA@AgNPs RO) was prepared with GA as the stabilizer for AgNPs and MPD as the reducing agent. The results show that this new method enables the uniform distribution of AgNPs in the GA units connected to the polyamide layer. As a result, the modified polyamide RO membrane has a strong ability to resist biofouling.
Our strategy was designed based on the multi-functional capability of MPD. MPD monomers containing primary amine groups, which are used to form the main polyamide network, can also act as a reducing agent to produce AgNPs. We applied GA@AgNPs to RO membranes to prepare RO membranes with uniformly dispersed AgNPs. This research contributes to the theory and practice of antibacterial RO membrane preparation, which is beneficial for freshwater production and environmental protection.
2 Materials and methods
2.1 Materials and reagents
The PSF ultrafiltration membrane with a molecular weight cutoff of 20,000 Da was provided by Zhongke Ruiyang Membrane Technology (Beijing) Co., Ltd. GA, camphorsulfonic acid (CAS), MPD, and 1,3,5-benzenetricarbonyl chloride (TMC) were obtained from Shanghai McLean Biochemical Technology Co., Ltd. AgNO3 (AgNO3) was provided by Tianjin Obokai Chemical Co., Ltd. Triethylamine (TEA) and sodium chloride (NaCl) were provided by Tianjin Damao Chemical Reagent Factory. n-Hexane was provided by Tianjin Aopusheng Chemical Co., Ltd. Escherichia coli and Staphylococcus aureus were used for the antibacterial experiments and were provided by Guangdong Huankai Microbial Technology Co., Ltd. All solvents and reagents were of analytical grade.
2.2 Preparation of the antibacterial membrane
The GA@AgNPs RO membrane was prepared by interfacial polymerization in five steps, as shown in Figure 1.
Cleaning the fine pores on the surface of a PSF membrane. A PSF basement membrane was immersed in absolute ethanol and deionized water for 24 h to clean its fine pores, respectively.
Generation of a compound of AgGA. A total of 20 mL of a 0.2% AgNO3 water solution was mixed with 20 mL of 0.5% of GA water solution. Therefore, a reaction occurs to generate their AgGA salt, which results in a uniform dispersion of silver ions in the GA molecules.
Preparation of a mixed water solution. A total of 20 mL of 2.0 wt% MPD, 20 mL of 2.2% CAS, and 20 mL of 1.3% triethylamine were mixed evenly to generate a mixed water solution.
Generation of a composition of AgNPs with GA. The generated compound of AgGA was added to the mixed water solution mentioned earlier. AgNPs were generated by the reducing reaction between MPD and the compound of AgGA. At the same time, the generated AgNPs were kept coordinated by the hydroxyl groups of GA, expressed as GA@AgNPs. Hence, AgNPs are uniformly dispersed.
Preparation of GA@AgNPs RO membrane. The cleaned PSF membrane surface was soaked in the above suspension containing GA@AgNPs for 5 min, and the excess suspension was removed. Then, 20 mL of 0.1 wt% TMC organic solution was poured onto the soaked PSF membrane surface. The excess organic solution was removed after 80 s of the reaction. The composite RO membrane was dried in an oven at 60°C for 10 min. Therefore, a composite RO membrane was prepared completely, which was mainly composed of a polyamide membrane containing the composition of GA@AgNPs, expressed as (GA@AgNPs RO).

The process of preparation of the antibacterial RO membrane.
2.3 Characterization
2.3.1 Transmission electron microscope (TEM)
The AgNPs prepared in the experimental Step 4 were washed and dried to obtain clean AgNPs. To characterize the size and morphology of AgNPs, samples were prepared by drying a drop of AgNPs suspension in ethanol in a darkroom on a 230-mesh amorphous carbon-coated copper grid and analyzed under a TEM (JEOL F200, Japan) with a lanthanum hexaboride electron gun operating at 120 kV.
2.3.2 X-ray diffraction (XRD)
The AgNPs powder samples were characterized by XRD. Among them, the radiation source used was Cu Kα (α = 1.54178 Å), the tube voltage was 40 kV, the tube current was 40 mA, the scanning range was 2θ = 10–80°, and the measurement was performed at a speed of 2°·min−1.
2.3.3 Scanning electron microscopy (SEM)
SEM was used to observe the surface structure of the membrane material. First, the prepared membrane was completely dried in a vacuum drying oven at 60°C for 6 h. Then, the membrane was cut into an area of 0.25 cm2 as the test sample. The scanning voltage was set to 10 kV, and the magnification range was 1,000 times to 60,000 times.
2.3.4 Atomic force microscopy (AFM)
AFM was used to quantitatively characterize the roughness of the membrane material. As a test sample, a dry membrane was cut into each 1 cm2 and fixed on the sample stage with double-sided tape before being analyzed by an AFM in the range of 20 μm × 20 μm.
2.3.5 Energy dispersive X-ray spectrometer (EDX)
EDX was used to characterize the elements contained in the sample of the modified membrane.
2.3.6 Fourier transform infrared spectroscopy (FTIR)
FTIR was used to measure the infrared absorption peaks of functional groups on the surface of membrane materials. The dry membrane was cut into an appropriate size and placed directly into the sample table for a test by the wavelength of 400–6,000 cm−1.
2.3.7 X-ray photoelectron spectroscopy (XPS)
XPS was used to characterize the constituent elements and characteristic element valence that stayed on the surface of the membrane material. The membrane material was thoroughly scanned in the energy range of 0–1,350 eV. Then, the energy range of the main elements of the membrane material was scanned in high resolution. Avantage software was used to perform peak-fitting processing on the data of the characteristic peaks of the Ag element. The valence information of the Ag element in the membrane material was analyzed.
2.3.8 UV-Vis diffuse reflectance spectrometer (UV-Vis DRS)
The UV-3600Plus ultraviolet-visible diffuse reflectance spectrometer produced by Shimadzu Corporation was used to conduct ultraviolet diffuse reflectance spectroscopic analysis on the RO membrane to explore the stability of the membrane. In the test, BaSO4 was used as a reference, the integrating sphere was used as a carrier, the slit width of the instrument was set to 600 nm·min−1, and the absorbance of the sample in the wavelength range of 200–800 nm was measured.
2.4 Separation performance testing
The separation performance of the RO membrane was tested by a cross-flow RO membrane device, as shown in Figure 2. The raw water was the sodium chloride sample with a mass concentration of 2,000 mg·L−1 and a pH of 7.5 ± 0.5. The membrane samples were installed in the membrane tank and operated at 1.5 MPa for 30 min to achieve a stable flux. The water flux (J, L·m−2·h−1) and desalinization rate (R, %) were calculated as shown in Eqs. 1 and 2, respectively:
where V was the volume of the permeate (L); A was the effective membrane area of the membrane (2.827 × 10−3 m2); t was the permeation time (h); C p and C f are the conductivity of the permeate and the raw material, respectively (μs·cm−1).

Flow chart of the test device for the permeability of the generated RO membrane.
2.5 Antibacterial experiment
In this study, the antimicrobial properties of the membranes were evaluated with two types of bacteria (E. coli and S. aureus). The membrane sample was cut into a rectangle of 7.6 cm × 2.5 cm (the same size as the glass slide). The membrane, slide, and petri dish were sterilized by UV light irradiation for 2 h. Then, an alcohol lamp was lit on an ultra-clean workbench. The following procedures were performed in a sterile environment: 100 μL of bacterial suspension was evenly dispersed, with a bacterial concentration of about 1.0 × 107 cfu·mL−1 E. coli and S. aureus on the surface of the membrane. The membrane was lightly covered with a glass slide to ensure that the bacterial solution is evenly dispersed and not volatile. Seal the slide-covered membrane in a sterile Petri dish and place it in a constant temperature incubator at 37°C for 2 h. The membrane and slide were taken out and put into a centrifuge tube containing 20 mL of sterile normal saline and shaken well to ensure that the bacteria on the membrane and slide were completely flushed into the physiological saline. A 100 μL of the well-mixed rinse solution was taken and evenly spread on a sterile, LB solid medium. After culturing in a constant temperature incubator at 37°C for 24 h, record the number of colonies on the medium (A).
Blank control group: a 1.0 × 107-cfu·mL−1 bacterial suspension that was not in contact with the membrane was placed in a constant temperature incubator at 37℃ for 2 h. Then, a 100 μL of bacterial suspension was taken and dissolved in 20 mL of sterile saline and shaken well to mix well. A 100 μL of the diluted solution, mixed evenly, was taken and spread on a sterile LB solid medium. After culturing in a constant temperature incubator at 37℃ for 24 h, record the number of colonies on the solid medium (B). The bactericidal performance of the RO membrane is characterized by the bacterial mortality rate (M), which can be calculated as follows:
where A was the number of colonies eluted when the bacterial suspension was in contact with the membrane surface for 2 h and B was the number of colonies obtained when the bacterial suspension was in contact without the membrane surface for 2 h (blank control group).
3 Results
3.1 Characterization of AgNPs
3.1.1 Morphology and particle size analysis of AgNPs
The surface properties of AgNPs were analyzed using the TEM technique. Figure 3a and b depicts the TEM images (a) and particle size distribution images (b) of AgNPs. Figure 3a shows that the AgNPs are spherical with a layer of coating on the outside. This indicated that AgNPs were coated with GA to form GA@AgNPs particles. Furthermore, the AgNPs show a well-resolved, (111) lattice fringe (d = 0.235 nm), face-centered cubic structure, implying that the AgNPs are face-centered cubic metallic silver. Figure 3b is the size distribution histogram of AgNPs analyzed from the TEM images. As shown in Figure 3b, the particle size distribution of AgNPs ranged from 6.7 to 30.4 nm, with an average particle size of 15.1 nm.

HRTEM images of AgNPs (a) and size distribution histograms (b).
3.1.2 Results of XRD analysis
The structural properties of AgNPs were analyzed using the XRD technique. As shown in Figure 4, the XRD spectrum of AgNPs has absorption peaks at 38.15°, 44.29°, 64.61°, and 77.26°, which is consistent with the data on JCPDS card 04-0783 (38.096°, 44.257°, 64.406°, and 77.452°) are basically consistent, corresponding to (111), (200), (220), and (311) crystal planes of cubic silver, respectively, indicating that the product is pure-phase elemental silver of a face-centered cubic system. The four absorption peaks of this curve are more obvious and sharp, which shows that the prepared AgNPs have good crystallinity. The size of AgNPs is estimated to be 9.8 nm from the full width at the half maximum of the (111) reflection according to the Debye–Scherrer formula. The size is slightly smaller than the average particle diameter measured by TEM images. This is because the AgNPs on the TEM have a coating layer, resulting in a larger measured size than the actual size.

XRD patterns of AgNPs.
3.2 The structure of the generated GA@AgNPs RO membrane
3.2.1 Morphology of the generated membrane surface
Figure 5a and b shows the SEM and AFM images of the GA@AgNPs RO membrane. As a comparison, Figure 5c and d shows the SEM and AFM images of the original RO membrane prepared only by the polyamide.

SEM and AFM images of the generated RO membrane compared with the original RO membrane.
As shown in Figure 5a and b, there were many raised structures on the surface of the GA@AgNPs RO membrane. Most of these raised structures are densely distributed closed rings. By comparison, the sizes of the raised structures on the surface of the GA@AgNPs RO membrane were smaller than those of the original RO membrane prepared only by polyamide. However, the number of the raised structures increased significantly, as shown in Figure 5c and d. Therefore, the total passed surface and surface roughness of the membrane were significantly increased, leading to an increase in permeability (15).
3.2.2 Element distribution on the membrane surface
An energy dispersive spectroscopy (EDS) technique was applied to investigate the dispersibility of the AgNPs and other elements in the generated membrane. The EDS image of the GA@AgNPs RO membrane is shown in Figure 6.

EDS image of the GA@AgNPs RO membrane.
As shown in Figure 6, the distribution of the Ag element is uniform. Therefore, it indicated that the AgNPs were uniformly distributed on the membrane. In addition, the other elements of C, N, and O were uniformly distributed on the membrane, which means that the compositions of GA and MDP were mixed evenly in the membrane, where the AgNPs were encapsulated in the polyamide network. This is beneficial to the stable existence of AgNPs in the GA@AgNPs RO membrane.
3.2.3 Results of FTIR analysis
The FTIR spectra of the PSF membrane (blue curve), the original RO membrane by polyamide (red curve), and the GA@AgNPs RO membrane (black curve) are shown in Figure 7.

ATR-FTIR scanning pattern on the membrane surface.
The special peaks in the spectra of the GA@AgNPs RO membrane were identified by comparison with the spectra of the PSF membrane and the original RO membrane by polyamide. The sharp peak at 1,684 cm−1 was assigned to aromatic ketones. They were formed by the oxidation of GA in an alkaline solution. The peak at 1,170 cm−1 belongs to the O═S═O group in the PSF membrane. The peaks at 1,658, 1,541, and 1,610 cm−1 were corresponding to the C═O (amide I) stretching vibration peak, the N–H (amide II) plane bending vibration peak in the amide bond, and the C═O (amide I) associated with hydrogen bonds of the stretching vibration peak (16,17). These characteristic absorption peaks of typical aromatic polyamides confirm the successful preparation of polyamide separation layers on PSF membranes (18).
The peaks at 1,658, 1,541, and 1,610 cm−1 were all slightly enhanced compared to the RO membrane by only polyamide, indicating increased amide bonds. Due to the amide reaction between the carboxyl group on the GA units and the amine group on the MPD units in the mixed water solution. Therefore, the FTIR results confirmed that GA was successfully connected to the GA@AgNPs RO membrane.
3.2.4 The existence of the formation of Ag element
The changes in the chemical composition of the surface of the generated RO membrane were calculated by XPS analysis. Figure 8a shows the full XPS spectra of the original RO membrane by polyamide (black curve), the GA-RO membrane (blue curve), and the generated GA@AgNPs RO membrane (red curve). Figure 8b shows the peak deconvolution of the narrow-scan XPS spectrum of the GA@AgNPs RO membrane.

XPS spectra of the generated GA@AgNPs RO membranes (a) and the existence formation of Ag element (b).
It can be observed in Figure 8a that the spectra of these three samples were very similar. The spectrum of the GA@AgNPs RO membrane presented two new peaks of Ag 3d3/2 and Ag 3d5/2 with binding energies of 374 and 368 eV, respectively, which indicated the presence of silver atoms (19). It can be seen in Figure 8b that, except for Ag, almost no peaks of other chemical states exist in the spectrum, which further indicates the existence of the formation of AgNPs on the membrane surface. Therefore, the results of the XPS analysis confirmed that AgNPs were successfully introduced onto the RO membrane.
3.2.5 The structure model of the generated GA@AgNPs RO membrane
Based on the results of SEM, AFM, FTIR, and XPS analysis and the chemical reactions principles, the structure model of the generated GA@AgNPs RO membrane can be established as shown in Figure 9.

The structure model of the GA@AgNPs RO membrane.
3.3 The performance of the GA@AgNPs RO membrane
The water flux of the GA@AgNPs RO membrane was 31.1 L·m−2·h−1, which was 46.7% higher than that of the original membrane, which was prepared on the PSF basement membrane by adding a mixed solution with TEA, CAS, MPD, and TMC. The salt rejection rate by the GA@AgNPs RO membrane remained between 93.8% and 97.6%.
The reason for the increase of water flux through the GA@AgNPs membrane is as follows: on the one hand, the AFM analysis shows that the doping of GA@AgNPs increases the roughness of the membrane, thus increasing the contact area between the membrane and water molecules, which is conducive to the penetration of water molecules. On the other hand, some voids generated between the AgNPs and polyamide layers can provide additional nanochannels for the fast transport of water molecules, thereby enhancing the water flux of the membrane. Moreover, it has a strong inhibitory ability against microorganisms. The bacteriostatic rate of GA@AgNPs RO membrane against E. coli and S. aureus was above 99.9%, which was calculated based on the results of E. coli colonies and S. aureus colonies as shown in Figure 10.
Photographs of the bacterial culture plates of E. coli (a–c) and S. aureus (d–f) for virgin (a and d), original RO membrane (b and e), and GA@AgNPs RO membrane (c and f).
There are four reasons for the strong antibacterial ability. First, the GA@AgNPs RO membrane contains AgNPs. Those AgNPs can attach to bacterial surfaces and penetrate into bacteria, thereby destroying living bacteria (20). Second, AgNPs can generate reactive oxygen species to disrupt DNA replication (21). Third, the toxicity of AgNPs can be driven by the release of silver ions, which can easily combine with the sulfhydryl groups on bacterial cell membranes, thereby inhibiting cellular enzyme activity (9,22). Fourth, silver ions can activate oxygen molecules in air or water to generate hydroxyl radicals and superoxide radicals, which can further oxidize and kill bacteria without illumination (20).
3.4 The stability of GA@AgNPs RO membrane
The GA@AgNPs RO stability was analyzed using UV-Vis DRS. Figure 11 shows the UV-Vis diffuse reflection spectrum of the GA@AgNPs RO membrane at different time periods, which characterizes the light absorption properties of the GA@AgNPs RO membrane. As shown in Figure 11, the GA@AgNPs RO membrane has strong light absorption ability in the UV-Vis range, and the absorption edges are 271 nm. It can be seen from Figure 11 that the UV absorption peaks of the prepared GA@AgNPs RO membranes after being placed for 1, 5, 15, and 25 days have similar peak shapes and their half-peak widths basically do not change, indicating that the GA@AgNPs RO membranes have good stability.

UV-Vis diffuse reflection spectrum of GA@AgNPs RO membrane at different time periods.
3.5 Discussions on the reaction mechanisms of AgNPs generation
Based on the SEM and AFM images, it can be seen that there are many convex structures on the surface of the original RO membrane. Those raised structures were a typical feature of the active layer on the surface of the aromatic polyamide composite membrane via MPD and TMC as the monomers. However, when the original RO membrane touched a silver nitrogen solution, some of the raised structures drew back. As the amino groups on the polyamide units react with silver ions, the substances in the raised structures are agglomerated. Thus, it strongly affects the permeability and desalination rate of the RO membrane. Therefore, it indicated that directly applied silver ions to the original RO membrane were not proposed.
For this reason and based on the inspired by literature, we got an idea of using GA to react with silver nitrogen solution to generate a kind of stable AgNPs for the antibacterial property of the RO membrane. The reaction mechanisms can be explained as follows.
First, silver nitrogen dissociated into silver ions and nitrate anions. Then, dissociated silver ions were coordinated by the hydroxyl groups on GA molecules. As a result, it caused a decentralization of silver ions and avoided connecting silver ions directly to amino compounds to generate an agglomeration. The reactions can be expressed as follows:
Second, the intermediate product of Ag+GA was reduced to generate AgNPs by the reduction of MPD, which converted to m-dinitrobenzene (MD) (23,24,25,26). The reactions can be expressed as Eq. 6. By the way, AgNPs were successfully formed. The generated AgNPs were also coordinated by the hydroxyl groups on the GA molecules in the water solution, resulting in an even decentralization of the AgNPs. This judgment was supported by literature and the XPS characterization mentioned earlier.
3.6 Discussion on the advance and shortage of this research
A new type of RO membrane was successfully prepared by a simple method, and a high-quality RO membrane with higher permeability and higher antibacterial ability was obtained. In contrast, Yang et al. and Ben-Sasson et al. reduced silver ions using the strong reducing agent NaBH4 (11,12). In this article, we focus on the multifunctional design of MPD, where the MPD monomer contains primary amine groups for forming the main polyamide network while also acting as a reducing agent for silver ions. Therefore, it provides a new idea for the reduction of silver ions, avoiding the use of additional toxic reducing agents and bridging agents. We applied GA@AgNPs to the RO membrane and realized the uniform dispersion of AgNPs on the RO membrane. In addition, the GA@AgNPs RO membrane preparation method only needs to add modified materials based on the traditional RO preparation process. We synthesized an RO membrane with uniformly dispersed AgNPs in one step through interfacial polymerization, which improved the antibacterial and permeability properties of the RO membrane. Therefore, the developed method is simple and easy to industrialize.
Based on the results of SEM, AFM, FTIR, and XPS analyses, as well as the chemical structures of the generated products, we developed a structural model of the generated GA@AgNPs RO membrane and revealed the reaction mechanism of GA with silver nitrogen. This provides a scientific theory and technology for the preparation and dispersion of AgNPs that inhibits microorganisms in the membrane industry. However, our work does not explore the performance of the membranes in practical applications. Further studies are needed before GA@AgNPs RO membranes can be put on the market.
4 Conclusions
A novel GA@AgNPs RO membrane was fabricated by incorporating GA-modified AgNPs into the polyamide layer during interfacial polymerization. The doped GA-modified AgNPs can be uniformly dispersed on the membrane, and the roughness of the membrane is increased, so that the water flux of the membrane increases to 31.1 L·m−2·h−1, which is 46.7% higher than that of the original membrane. The rejection performance of the GA@AgNPs RO membrane was not affected, and the salt rejection rate remained at 93.8–97.6%. In addition, due to the intrinsic properties of AgNPs, the bactericidal activity of GA@AgNPs RO membrane was significantly enhanced, and the inhibition rate against both E. coli and S. aureus exceeded 99.9%.
Acknowledgement
The authors would like to thank the National Natural Science Foundation of China and the Guangxi Science and Technology Foundation for research funding.
-
Funding information: This project is supported by the National Natural Science Foundation of China (Grant No. 21868006) and the Guangxi Science and Technology Foundation (Grant No. AA17204067).
-
Author contributions: Zou Xiaofang: writing – original draft, writing – review and editing, methodology, visualization, formal analysis; Tian Zhu: formal analysis, methodology; Tang Jiangquan: formal analysis, methodology; Weixing Gan: project administration, funding acquisition; Guangzai Nong: project administration, writing – review and editing, formal analysis, visualization, methodology, supervision.
-
Conflict of interest: The authors state that there is no conflict of interest.
-
Data availability statement: All data generated or analyzed during this study are included in this published article.
References
(1) Misdan N, Lau WJ, Ismail AF. Seawater Reverse Osmosis (SWRO) desalination by thin-film composite membrane – Current development, challenges and future prospects. Desalination. 2012;287:287228–37. 10.1016/j.desal.2011.11.001.Search in Google Scholar
(2) Patel SK, Ritt CL, Deshmukh A, Wang Z, Qin M, Epsztein R, et al. The relative insignificance of advanced materials in enhancing the energy efficiency of desalination technologies. Energy Environ Sci. 2020;13(6):1694–710. 10.1039/d0ee00341g.Search in Google Scholar
(3) Huang X, Chen Y, Feng X, Hu X, Zhang Y, Liu L. Incorporation of oleic acid-modified Ag@ZnO core-shell nanoparticles into thin film composite membranes for enhanced antifouling and antibacterial properties. J Membr Sci. 2020;602:117956. 10.1016/j.memsci.2020.117956.Search in Google Scholar
(4) Matin A, Khan Z, Zaidi SMJ, Boyce MC. Biofouling in reverse osmosis membranes for seawater desalination: Phenomena and prevention. Desalination. 2011;281:2811–16. 10.1016/j.desal.2011.06.063.Search in Google Scholar
(5) Prihasto N, Liu Q-F, Kim S-H. Pre-treatment strategies for seawater desalination by reverse osmosis system. Desalination. 2009;249(1):308–16. 10.1016/j.desal.2008.09.010.Search in Google Scholar
(6) Kochkodan V, Hilal N. A comprehensive review on surface modified polymer membranes for biofouling mitigation. Desalination. 2015;356:356187–207. 10.1016/j.desal.2014.09.015.Search in Google Scholar
(7) Zhang C, Hu Z, Deng B. Silver nanoparticles in aquatic environments: Physiochemical behavior and antimicrobial mechanisms. Water Res. 2016;88:88403–27. 10.1016/j.watres.2015.10.025.Search in Google Scholar PubMed
(8) Shuai C, Guo W, Wu P, Yang W, Hu S, Xia Y, et al. A graphene oxide-Ag co-dispersing nanosystem: Dual synergistic effects on antibacterial activities and mechanical properties of polymer scaffolds. Chem Eng J. 2018;347:347322–33. 10.1016/j.cej.2018.04.092.Search in Google Scholar
(9) Chernousova S, Epple M. Silver as antibacterial agent: Ion, nanoparticle, and metal. Angew Chem Int Ed. 2013;52(6):1636–53. 10.1002/anie.201205923.Search in Google Scholar PubMed
(10) Yin J, Yang Y, Hu Z, Deng B. Attachment of silver nanoparticles (AgNPs) onto thin-film composite (TFC) membranes through covalent bonding to reduce membrane biofouling. J Membr Sci. 2013;441:44173–82. 10.1016/j.memsci.2013.03.060.Search in Google Scholar
(11) Ben-Sasson M, Lu X, Bar-Zeev E, Zodrow KR, Nejati S, Qi G, et al. In situ formation of silver nanoparticles on thin-film composite reverse osmosis membranes for biofouling mitigation. Water Res. 2014;62:62260–70. 10.1016/j.watres.2014.05.049.Search in Google Scholar PubMed
(12) Yang Z, Takagi R, Zhang XY, Yasui T, Zhang L, Matsuyama H. Engineering a dual-functional sulfonated polyelectrolyte-silver nanoparticle complex on a polyamide reverse osmosis membrane for robust biofouling mitigation. J Membr Sci. 2021;618:118757. 10.1016/j.memsci.2020.118757.Search in Google Scholar
(13) Kahkeshani N, Farzaei F, Fotouhi M, Alavi SS, Bahramsoltani R, Naseri R, et al. Pharmacological effects of gallic acid in health and diseases: A mechanistic review. Iran J Basic Med Sci. 2019;22(3):225–37. 10.22038/ijbms.2019.32806.7897.Search in Google Scholar PubMed PubMed Central
(14) Tamuly C, Hazarika M, Borah SC, Das MR, Boruah MP. In situ biosynthesis of Ag, Au and bimetallic nanoparticles using Piper pedicellatum C.DC: Green chemistry approach. Colloid Surf B. 2013;102:102627–34. 10.1016/j.colsurfb.2012.09.007.Search in Google Scholar PubMed
(15) Ramon GZ, Hoek EMV. Transport through composite membranes, part 2: Impacts of roughness on permeability and fouling. J Membr Sci. 2013;425-426:425141–8. 10.1016/j.memsci.2012.08.004.Search in Google Scholar
(16) Tang CYY, Kwon YN, Leckie JO. Effect of membrane chemistry and coating layer on physiochemical properties of thin film composite polyamide RO and NF membranes I. FTIR and XPS characterization of polyamide and coating layer chemistry. Desalination. 2009;242(1–3):149–67. 10.1016/j.desal.2008.04.003.Search in Google Scholar
(17) Zou H, Jin Y, Yang J, Dai HJ, Yu XL, Xu J. Synthesis and characterization of thin film composite reverse osmosis membranes via novel interfacial polymerization approach. Sep Purif Technol. 2010;72(3):256–62. 10.1016/j.seppur.2010.01.019.Search in Google Scholar
(18) Kang GD, Yu HJ, Liu ZN, Cao YM. Surface modification of a commercial thin film composite polyamide reverse osmosis membrane by carbodiimide-induced grafting with poly(ethylene glycol) derivatives. Desalination. 2011;275(1–3):252–9. 10.1016/j.desal.2011.03.007.Search in Google Scholar
(19) Huang LC, Zhao S, Wang Z, Wu JH, Wang JX, Wang SC. In situ immobilization of silver nanoparticles for improving permeability, antifouling and anti-bacterial properties of ultrafiltration membrane. J Membr Sci. 2016;499:499269–81. 10.1016/j.memsci.2015.10.055.Search in Google Scholar
(20) Kedziora A, Speruda M, Krzyzewska E, Rybka J, Lukowiak A, Bugla-Ploskonska G. Similarities and differences between silver ions and silver in nanoforms as antibacterial agents. Int J Mol Sci. 2018;19(2):444. 10.3390/ijms19020444.Search in Google Scholar PubMed PubMed Central
(21) Duran N, Duran M, De Jesus MB, Seabra AB, Favaro WJ, Nakazato G. Silver nanoparticles: A new view on mechanistic aspects on antimicrobial activity. Nanomed Nanotechnol. 2016;12(3):789–99. 10.1016/j.nano.2015.11.016.Search in Google Scholar PubMed
(22) Sambhy V, Macbride MM, Peterson BR, Sen A. Silver bromide nanoparticle/polymer composites: Dual action tunable antimicrobial materials. J Am Chem Soc. 2006;128(30):9798–808. 10.1021/ja061442z.Search in Google Scholar PubMed
(23) Tian J, Luo Y, Li H, Lu W, Chang G, Qin X, et al. Ag@poly(m-phenylenediamine)-Ag core-shell nanoparticles: one-step preparation, characterization, and their application for H2O2 detection. Catal Sci Technol. 2011;1(8):1393–8. 10.1039/c1cy00212k.Search in Google Scholar
(24) Zhang YW, Wang L, Tian JQ, Li HL, Luo YL, Sun XP. Ag@Poly(m-phenylenediamine) core-shell nanoparticles for highly selective, multiplex nucleic acid detection. Langmuir. 2011;27(6):2170–5. 10.1021/la105092f.Search in Google Scholar PubMed
(25) He Y, Huang L, Zhao Y, Yang W, Hao T, Wu B, et al. A newly synthesized highly stable Ag/N-carbon electrode for enhanced desalination by capacitive deionization. Environ Sci Nano. 2020;7(10):3007–19. 10.1039/d0en00826e.Search in Google Scholar
(26) Zhang L, Chai L, Liu J, Wang H, Yu W, Sang P. pH Manipulation: A facile method for lowering oxidation state and keeping good yield of poly(m-phenylenediamine) and its powerful Ag+ adsorption ability. Langmuir. 2011;27(22):13729–38. 10.1021/la203162y.Search in Google Scholar PubMed
© 2023 the author(s), published by De Gruyter
This work is licensed under the Creative Commons Attribution 4.0 International License.
Articles in the same Issue
- Research Articles
- Chitosan nanocomposite film incorporating Nigella sativa oil, Azadirachta indica leaves’ extract, and silver nanoparticles
- Effect of Zr-doped CaCu3Ti3.95Zr0.05O12 ceramic on the microstructure, dielectric properties, and electric field distribution of the LDPE composites
- Effects of dry heating, acetylation, and acid pre-treatments on modification of potato starch with octenyl succinic anhydride (OSA)
- Loading conditions impact on the compression fatigue behavior of filled styrene butadiene rubber
- Characterization and compatibility of bio-based PA56/PET
- Study on the aging of three typical rubber materials under high- and low-temperature cyclic environment
- Numerical simulation and experimental research of electrospun polyacrylonitrile Taylor cone based on multiphysics coupling
- Experimental investigation of properties and aging behavior of pineapple and sisal leaf hybrid fiber-reinforced polymer composites
- Influence of temperature distribution on the foaming quality of foamed polypropylene composites
- Enzyme-catalyzed synthesis of 4-methylcatechol oligomer and preliminary evaluations as stabilizing agent in polypropylene
- Molecular dynamics simulation of the effect of the thermal and mechanical properties of addition liquid silicone rubber modified by carbon nanotubes with different radii
- Incorporation of poly(3-acrylamidopropyl trimethylammonium chloride-co-acrylic acid) branches for good sizing properties and easy desizing from sized cotton warps
- Effect of matrix composition on properties of polyamide 66/polyamide 6I-6T composites with high content of continuous glass fiber for optimizing surface performance
- Preparation and properties of epoxy-modified thermosetting phenolic fiber
- Thermal decomposition reaction kinetics and storage life prediction of polyacrylate pressure-sensitive adhesive
- Effect of different proportions of CNTs/Fe3O4 hybrid filler on the morphological, electrical and electromagnetic interference shielding properties of poly(lactic acid) nanocomposites
- Doping silver nanoparticles into reverse osmosis membranes for antibacterial properties
- Melt-blended PLA/curcumin-cross-linked polyurethane film for enhanced UV-shielding ability
- The affinity of bentonite and WO3 nanoparticles toward epoxy resin polymer for radiation shielding
- Prolonged action fertilizer encapsulated by CMC/humic acid
- Preparation and experimental estimation of radiation shielding properties of novel epoxy reinforced with Sb2O3 and PbO
- Fabrication of polylactic acid nanofibrous yarns for piezoelectric fabrics
- Copper phenyl phosphonate for epoxy resin and cyanate ester copolymer with improved flame retardancy and thermal properties
- Synergistic effect of thermal oxygen and UV aging on natural rubber
- Effect of zinc oxide suspension on the overall filler content of the PLA/ZnO composites and cPLA/ZnO composites
- The role of natural hybrid nanobentonite/nanocellulose in enhancing the water resistance properties of the biodegradable thermoplastic starch
- Performance optimization of geopolymer mortar blending in nano-SiO2 and PVA fiber based on set pair analysis
- Preparation of (La + Nb)-co-doped TiO2 and its polyvinylidene difluoride composites with high dielectric constants
- Effect of matrix composition on the performance of calcium carbonate filled poly(lactic acid)/poly(butylene adipate-co-terephthalate) composites
- Low-temperature self-healing polyurethane adhesives via dual synergetic crosslinking strategy
- Leucaena leucocephala oil-based poly malate-amide nanocomposite coating material for anticorrosive applications
- Preparation and properties of modified ammonium polyphosphate synergistic with tris(2-hydroxyethyl) isocynurate for flame-retardant LDPE
- Thermal response of double network hydrogels with varied composition
- The effect of coated calcium carbonate using stearic acid on the recovered carbon black masterbatch in low-density polyethylene composites
- Investigation of MXene-modified agar/polyurethane hydrogel elastomeric repair materials with tunable water absorption
- Damping performance analysis of carbon black/lead magnesium niobite/epoxy resin composites
- Molecular dynamics simulations of dihydroxylammonium 5,5′-bistetrazole-1,1′-diolate (TKX-50) and TKX-50-based PBXs with four energetic binders
- Preparation and characterization of sisal fibre reinforced sodium alginate gum composites for non-structural engineering applications
- Study on by-products synthesis of powder coating polyester resin catalyzed by organotin
- Ab initio molecular dynamics of insulating paper: Mechanism of insulating paper cellobiose cracking at transient high temperature
- Effect of different tin neodecanoate and calcium–zinc heat stabilizers on the thermal stability of PVC
- High-strength polyvinyl alcohol-based hydrogel by vermiculite and lignocellulosic nanofibrils for electronic sensing
- Impacts of micro-size PbO on the gamma-ray shielding performance of polyepoxide resin
- Influence of the molecular structure of phenylamine antioxidants on anti-migration and anti-aging behavior of high-performance nitrile rubber composites
- Fiber-reinforced polyvinyl alcohol hydrogel via in situ fiber formation
- Preparation and performance of homogenous braids-reinforced poly (p-phenylene terephthamide) hollow fiber membranes
- Synthesis of cadmium(ii) ion-imprinted composite membrane with a pyridine functional monomer and characterization of its adsorption performance
- Impact of WO3 and BaO nanoparticles on the radiation shielding characteristics of polydimethylsiloxane composites
- Comprehensive study of the radiation shielding feature of polyester polymers impregnated with iron filings
- Preparation and characterization of polymeric cross-linked hydrogel patch for topical delivery of gentamicin
- Mechanical properties of rCB-pigment masterbatch in rLDPE: The effect of processing aids and water absorption test
- Pineapple fruit residue-based nanofibre composites: Preparation and characterizations
- Effect of natural Indocalamus leaf addition on the mechanical properties of epoxy and epoxy-carbon fiber composites
- Utilization of biosilica for energy-saving tire compounds: Enhancing performance and efficiency
- Effect of capillary arrays on the profile of multi-layer micro-capillary films
- A numerical study on thermal bonding with preheating technique for polypropylene microfluidic device
- Development of modified h-BN/UPE resin for insulation varnish applications
- High strength, anti-static, thermal conductive glass fiber/epoxy composites for medical devices: A strategy of modifying fibers with functionalized carbon nanotubes
- Effects of mechanical recycling on the properties of glass fiber–reinforced polyamide 66 composites in automotive components
- Bentonite/hydroxyethylcellulose as eco-dielectrics with potential utilization in energy storage
- Study on wall-slipping mechanism of nano-injection polymer under the constant temperature fields
- Synthesis of low-VOC unsaturated polyester coatings for electrical insulation
- Enhanced apoptotic activity of Pluronic F127 polymer-encapsulated chlorogenic acid nanoparticles through the PI3K/Akt/mTOR signaling pathway in liver cancer cells and in vivo toxicity studies in zebrafish
- Preparation and performance of silicone-modified 3D printing photosensitive materials
- A novel fabrication method of slippery lubricant-infused porous surface by thiol-ene click chemistry reaction for anti-fouling and anti-corrosion applications
- Development of polymeric IPN hydrogels by free radical polymerization technique for extended release of letrozole: Characterization and toxicity evaluation
- Tribological characterization of sponge gourd outer skin fiber-reinforced epoxy composite with Tamarindus indica seed filler addition using the Box–Behnken method
- Stereocomplex PLLA–PBAT copolymer and its composites with multi-walled carbon nanotubes for electrostatic dissipative application
- Enhancing the therapeutic efficacy of Krestin–chitosan nanocomplex for cancer medication via activation of the mitochondrial intrinsic pathway
- Variation in tungsten(vi) oxide particle size for enhancing the radiation shielding ability of silicone rubber composites
- Damage accumulation and failure mechanism of glass/epoxy composite laminates subjected to repeated low velocity impacts
- Gamma-ray shielding analysis using the experimental measurements for copper(ii) sulfate-doped polyepoxide resins
- Numerical simulation into influence of airflow channel quantities on melt-blowing airflow field in processing of polymer fiber
- Cellulose acetate oleate-reinforced poly(butylene adipate-co-terephthalate) composite materials
- Radiation shielding capability and exposure buildup factor of cerium(iv) oxide-reinforced polyester resins
- Recyclable polytriazole resins with high performance based on Diels-Alder dynamic covalent crosslinking
- Adsorption and recovery of Cr(vi) from wastewater by Chitosan–Urushiol composite nanofiber membrane
- Comprehensive performance evaluation based on electromagnetic shielding properties of the weft-knitted fabrics made by stainless steel/cotton blended yarn
- Review Articles
- Preparation and application of natural protein polymer-based Pickering emulsions
- Wood-derived high-performance cellulose structural materials
- Flammability properties of polymers and polymer composites combined with ionic liquids
- Polymer-based nanocarriers for biomedical and environmental applications
- A review on semi-crystalline polymer bead foams from stirring autoclave: Processing and properties
- Rapid Communication
- Preparation and characterization of magnetic microgels with linear thermosensitivity over a wide temperature range
- Special Issue: Biodegradable and bio-based polymers: Green approaches (Guest Editors: Kumaran Subramanian, A. Wilson Santhosh Kumar, and Venkatajothi Ramarao)
- Synthesis and characterization of proton-conducting membranes based on bacterial cellulose and human nail keratin
- Fatigue behaviour of Kevlar/carbon/basalt fibre-reinforced SiC nanofiller particulate hybrid epoxy composite
- Effect of citric acid on thermal, phase morphological, and mechanical properties of poly(l-lactide)-b-poly(ethylene glycol)-b-poly(l-lactide)/thermoplastic starch blends
- Dose-dependent cytotoxicity against lung cancer cells via green synthesized ZnFe2O4/cellulose nanocomposites
Articles in the same Issue
- Research Articles
- Chitosan nanocomposite film incorporating Nigella sativa oil, Azadirachta indica leaves’ extract, and silver nanoparticles
- Effect of Zr-doped CaCu3Ti3.95Zr0.05O12 ceramic on the microstructure, dielectric properties, and electric field distribution of the LDPE composites
- Effects of dry heating, acetylation, and acid pre-treatments on modification of potato starch with octenyl succinic anhydride (OSA)
- Loading conditions impact on the compression fatigue behavior of filled styrene butadiene rubber
- Characterization and compatibility of bio-based PA56/PET
- Study on the aging of three typical rubber materials under high- and low-temperature cyclic environment
- Numerical simulation and experimental research of electrospun polyacrylonitrile Taylor cone based on multiphysics coupling
- Experimental investigation of properties and aging behavior of pineapple and sisal leaf hybrid fiber-reinforced polymer composites
- Influence of temperature distribution on the foaming quality of foamed polypropylene composites
- Enzyme-catalyzed synthesis of 4-methylcatechol oligomer and preliminary evaluations as stabilizing agent in polypropylene
- Molecular dynamics simulation of the effect of the thermal and mechanical properties of addition liquid silicone rubber modified by carbon nanotubes with different radii
- Incorporation of poly(3-acrylamidopropyl trimethylammonium chloride-co-acrylic acid) branches for good sizing properties and easy desizing from sized cotton warps
- Effect of matrix composition on properties of polyamide 66/polyamide 6I-6T composites with high content of continuous glass fiber for optimizing surface performance
- Preparation and properties of epoxy-modified thermosetting phenolic fiber
- Thermal decomposition reaction kinetics and storage life prediction of polyacrylate pressure-sensitive adhesive
- Effect of different proportions of CNTs/Fe3O4 hybrid filler on the morphological, electrical and electromagnetic interference shielding properties of poly(lactic acid) nanocomposites
- Doping silver nanoparticles into reverse osmosis membranes for antibacterial properties
- Melt-blended PLA/curcumin-cross-linked polyurethane film for enhanced UV-shielding ability
- The affinity of bentonite and WO3 nanoparticles toward epoxy resin polymer for radiation shielding
- Prolonged action fertilizer encapsulated by CMC/humic acid
- Preparation and experimental estimation of radiation shielding properties of novel epoxy reinforced with Sb2O3 and PbO
- Fabrication of polylactic acid nanofibrous yarns for piezoelectric fabrics
- Copper phenyl phosphonate for epoxy resin and cyanate ester copolymer with improved flame retardancy and thermal properties
- Synergistic effect of thermal oxygen and UV aging on natural rubber
- Effect of zinc oxide suspension on the overall filler content of the PLA/ZnO composites and cPLA/ZnO composites
- The role of natural hybrid nanobentonite/nanocellulose in enhancing the water resistance properties of the biodegradable thermoplastic starch
- Performance optimization of geopolymer mortar blending in nano-SiO2 and PVA fiber based on set pair analysis
- Preparation of (La + Nb)-co-doped TiO2 and its polyvinylidene difluoride composites with high dielectric constants
- Effect of matrix composition on the performance of calcium carbonate filled poly(lactic acid)/poly(butylene adipate-co-terephthalate) composites
- Low-temperature self-healing polyurethane adhesives via dual synergetic crosslinking strategy
- Leucaena leucocephala oil-based poly malate-amide nanocomposite coating material for anticorrosive applications
- Preparation and properties of modified ammonium polyphosphate synergistic with tris(2-hydroxyethyl) isocynurate for flame-retardant LDPE
- Thermal response of double network hydrogels with varied composition
- The effect of coated calcium carbonate using stearic acid on the recovered carbon black masterbatch in low-density polyethylene composites
- Investigation of MXene-modified agar/polyurethane hydrogel elastomeric repair materials with tunable water absorption
- Damping performance analysis of carbon black/lead magnesium niobite/epoxy resin composites
- Molecular dynamics simulations of dihydroxylammonium 5,5′-bistetrazole-1,1′-diolate (TKX-50) and TKX-50-based PBXs with four energetic binders
- Preparation and characterization of sisal fibre reinforced sodium alginate gum composites for non-structural engineering applications
- Study on by-products synthesis of powder coating polyester resin catalyzed by organotin
- Ab initio molecular dynamics of insulating paper: Mechanism of insulating paper cellobiose cracking at transient high temperature
- Effect of different tin neodecanoate and calcium–zinc heat stabilizers on the thermal stability of PVC
- High-strength polyvinyl alcohol-based hydrogel by vermiculite and lignocellulosic nanofibrils for electronic sensing
- Impacts of micro-size PbO on the gamma-ray shielding performance of polyepoxide resin
- Influence of the molecular structure of phenylamine antioxidants on anti-migration and anti-aging behavior of high-performance nitrile rubber composites
- Fiber-reinforced polyvinyl alcohol hydrogel via in situ fiber formation
- Preparation and performance of homogenous braids-reinforced poly (p-phenylene terephthamide) hollow fiber membranes
- Synthesis of cadmium(ii) ion-imprinted composite membrane with a pyridine functional monomer and characterization of its adsorption performance
- Impact of WO3 and BaO nanoparticles on the radiation shielding characteristics of polydimethylsiloxane composites
- Comprehensive study of the radiation shielding feature of polyester polymers impregnated with iron filings
- Preparation and characterization of polymeric cross-linked hydrogel patch for topical delivery of gentamicin
- Mechanical properties of rCB-pigment masterbatch in rLDPE: The effect of processing aids and water absorption test
- Pineapple fruit residue-based nanofibre composites: Preparation and characterizations
- Effect of natural Indocalamus leaf addition on the mechanical properties of epoxy and epoxy-carbon fiber composites
- Utilization of biosilica for energy-saving tire compounds: Enhancing performance and efficiency
- Effect of capillary arrays on the profile of multi-layer micro-capillary films
- A numerical study on thermal bonding with preheating technique for polypropylene microfluidic device
- Development of modified h-BN/UPE resin for insulation varnish applications
- High strength, anti-static, thermal conductive glass fiber/epoxy composites for medical devices: A strategy of modifying fibers with functionalized carbon nanotubes
- Effects of mechanical recycling on the properties of glass fiber–reinforced polyamide 66 composites in automotive components
- Bentonite/hydroxyethylcellulose as eco-dielectrics with potential utilization in energy storage
- Study on wall-slipping mechanism of nano-injection polymer under the constant temperature fields
- Synthesis of low-VOC unsaturated polyester coatings for electrical insulation
- Enhanced apoptotic activity of Pluronic F127 polymer-encapsulated chlorogenic acid nanoparticles through the PI3K/Akt/mTOR signaling pathway in liver cancer cells and in vivo toxicity studies in zebrafish
- Preparation and performance of silicone-modified 3D printing photosensitive materials
- A novel fabrication method of slippery lubricant-infused porous surface by thiol-ene click chemistry reaction for anti-fouling and anti-corrosion applications
- Development of polymeric IPN hydrogels by free radical polymerization technique for extended release of letrozole: Characterization and toxicity evaluation
- Tribological characterization of sponge gourd outer skin fiber-reinforced epoxy composite with Tamarindus indica seed filler addition using the Box–Behnken method
- Stereocomplex PLLA–PBAT copolymer and its composites with multi-walled carbon nanotubes for electrostatic dissipative application
- Enhancing the therapeutic efficacy of Krestin–chitosan nanocomplex for cancer medication via activation of the mitochondrial intrinsic pathway
- Variation in tungsten(vi) oxide particle size for enhancing the radiation shielding ability of silicone rubber composites
- Damage accumulation and failure mechanism of glass/epoxy composite laminates subjected to repeated low velocity impacts
- Gamma-ray shielding analysis using the experimental measurements for copper(ii) sulfate-doped polyepoxide resins
- Numerical simulation into influence of airflow channel quantities on melt-blowing airflow field in processing of polymer fiber
- Cellulose acetate oleate-reinforced poly(butylene adipate-co-terephthalate) composite materials
- Radiation shielding capability and exposure buildup factor of cerium(iv) oxide-reinforced polyester resins
- Recyclable polytriazole resins with high performance based on Diels-Alder dynamic covalent crosslinking
- Adsorption and recovery of Cr(vi) from wastewater by Chitosan–Urushiol composite nanofiber membrane
- Comprehensive performance evaluation based on electromagnetic shielding properties of the weft-knitted fabrics made by stainless steel/cotton blended yarn
- Review Articles
- Preparation and application of natural protein polymer-based Pickering emulsions
- Wood-derived high-performance cellulose structural materials
- Flammability properties of polymers and polymer composites combined with ionic liquids
- Polymer-based nanocarriers for biomedical and environmental applications
- A review on semi-crystalline polymer bead foams from stirring autoclave: Processing and properties
- Rapid Communication
- Preparation and characterization of magnetic microgels with linear thermosensitivity over a wide temperature range
- Special Issue: Biodegradable and bio-based polymers: Green approaches (Guest Editors: Kumaran Subramanian, A. Wilson Santhosh Kumar, and Venkatajothi Ramarao)
- Synthesis and characterization of proton-conducting membranes based on bacterial cellulose and human nail keratin
- Fatigue behaviour of Kevlar/carbon/basalt fibre-reinforced SiC nanofiller particulate hybrid epoxy composite
- Effect of citric acid on thermal, phase morphological, and mechanical properties of poly(l-lactide)-b-poly(ethylene glycol)-b-poly(l-lactide)/thermoplastic starch blends
- Dose-dependent cytotoxicity against lung cancer cells via green synthesized ZnFe2O4/cellulose nanocomposites